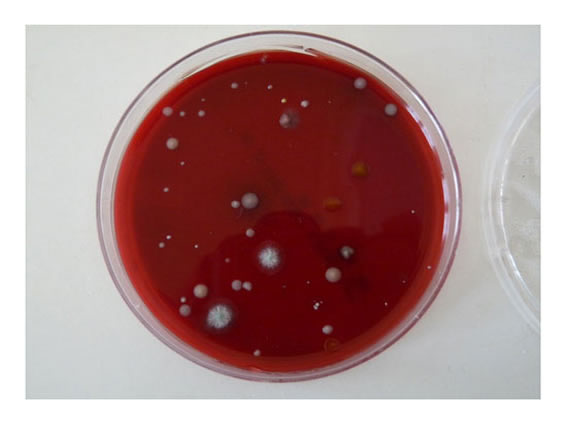
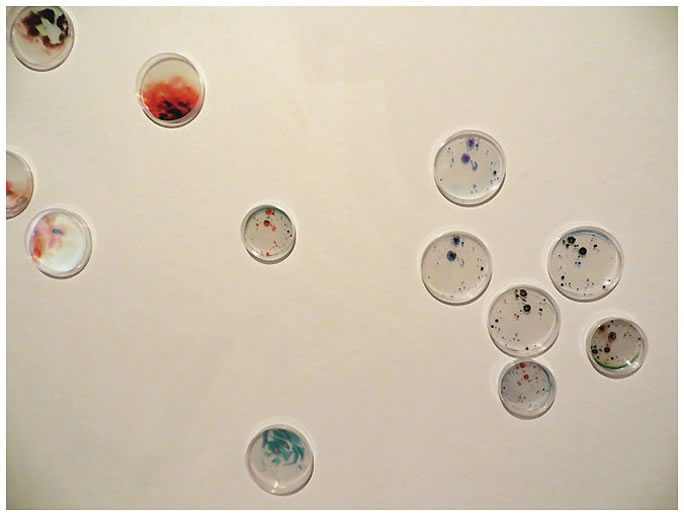

|


CRECIENTE
Obra basada en el desarrollo y crecimiento de diferentes tipos de bacterias como analogía del proceso creativo. En este caso, el azar y la aleatoriedad son determinantes en su evolución generando formaciones visibles a simple vista y que van más allá del aspecto propio de cada bacteria individual imperceptible a este nivel. Pero contrariamente a lo que se podría pensar las colonias siguen unas pautas regulares y ordenadas, semejantes al desarrollo de las comunidades humanas. Documentado fotográficamente durante 27 días; estas imágenes serán reelaboradas artísticamente, impresas y usadas para la edición del video.
Instalación, 2015
reproducción en bucle de 1 pieza video en monitor
diferentes piezas de fotografía tratada digitalmente sobre acetato
placas petri para crecimiento bacterianoMedidas variables